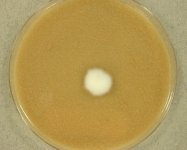

<< back to search
IMAGES:


Search Details
add to cart
| UAMH Number: | 11785 |
|---|---|
| Species Name: | Tulasnella sp. |
| Type: | |
| Synonyms: | Epulorhiza / Gloeotulasnella / Hormisciopsis / Hormomyces / Muciporus / Pachysterigma / Prototremella |
| Taxonomy: | FUNGI Basidiomycota, Agaricomycetes, Cantharellales, Tulasnellaceae |
| Strain History: | Zettler, L. (69-8) -> UAMH |
| Substrate: | roots of terrestrial orchid Cynorkis purpurea seedling, adjacent to stream, moist soil | Location: | MADAGASCAR Antsirakambiaty, dense forest remnant (GEO: -20.589,46.562) |
| Isolator: | (C) L.W. Zettler |
| Isolation Date: | 2013-05-03 |
| Date Received: | 2013-09-13 |
| Characters: | MOLECULAR SYSTEMATICS Blast match highest ITS similarity (98.8%) to uncultured Tulasnellaceae JF691515 - Yokoya K, Zettler LW, Kendon JP, Bidartondo MI, Stice AL, Skarha S, Corey LL, Knight AC, Viswambharan S, Mycorrhiza Epub 2015 Mar 14 // MOLECULAR SYSTEMATICS OTU tul4 // MYCORRHIZAE orchid endophyte Cynorkis purpurea |
| Compounds: | |
| Cross Reference: | |
| Pathogenic Potential: | Human: no | Animal: no | Plant: yes |
| Biosafety Risk Group: | RG1 (check the PHAC ePATHogen Risk Group Database for updates) |
| Regulatory Requirements: | Canadian requesters must provide PHAC Pathogen and Toxin License Number (see: https://www.canada.ca/en/public-health/services/laboratory-biosafety-biosecurity/licensing-program.html) prior to shipment. International requesters must provide all legally required importation documentation prior to shipment. Plant pathogenicity status may be verified by using the USDA Agricultural Research Service (ARS) Fungal Database |
| MycoBank ID: | 18695 |
IMAGES: